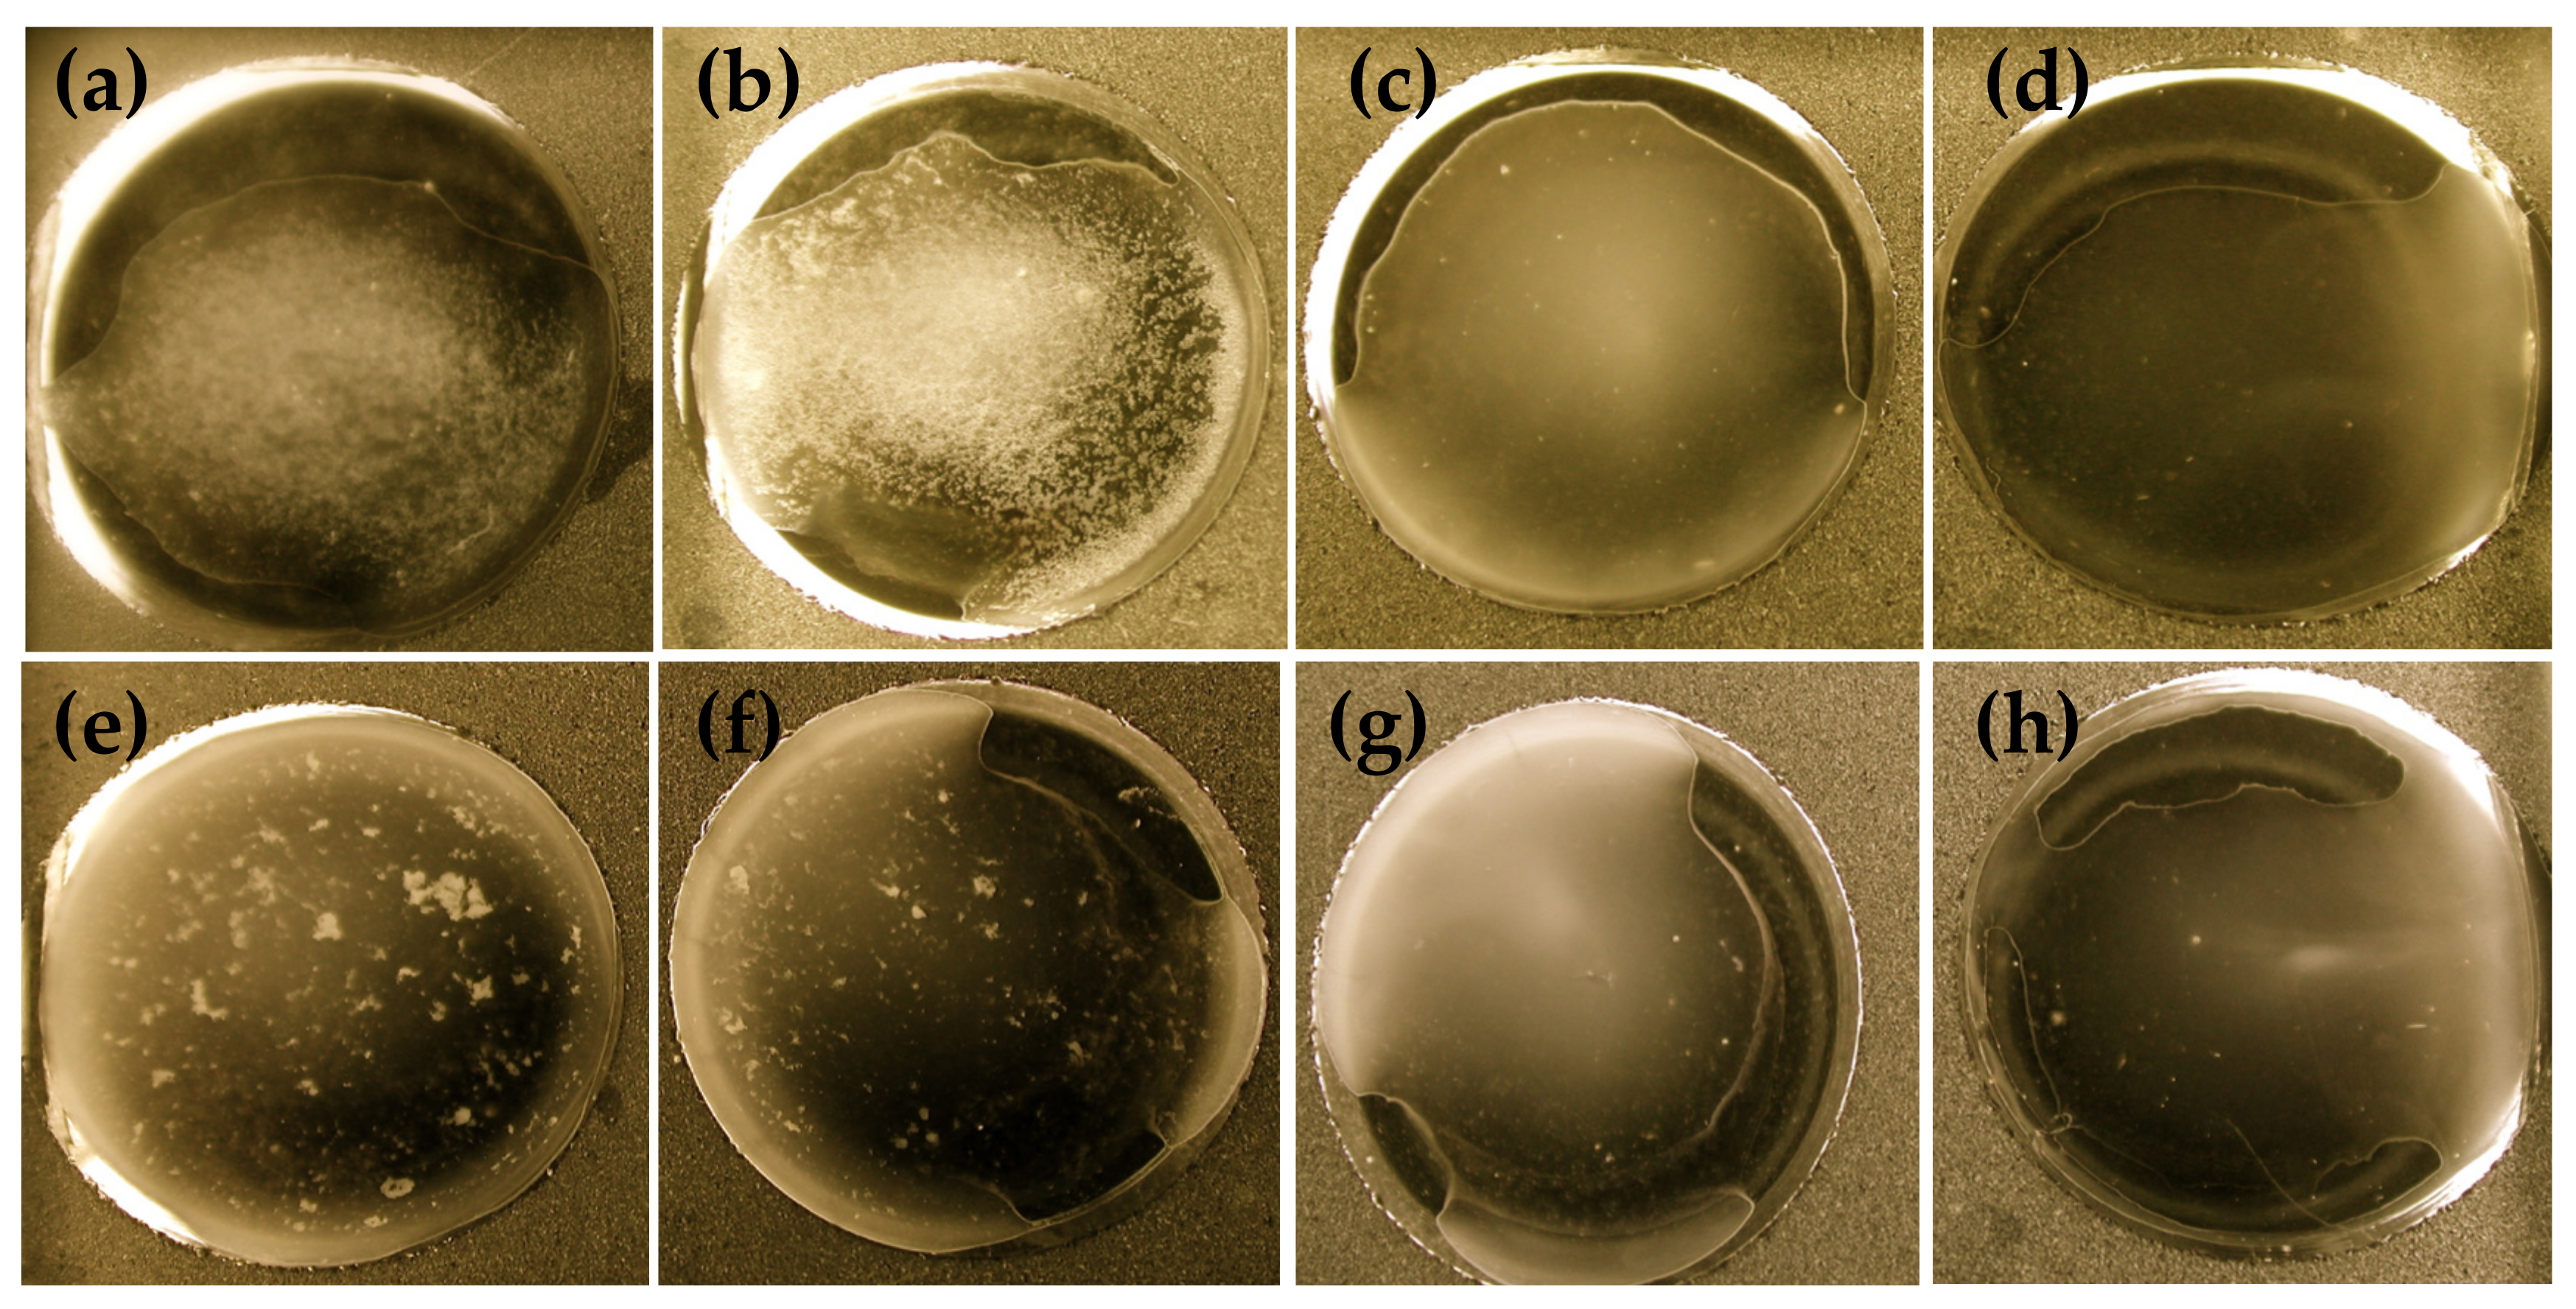
Agriculture 11 00186 g003 Agriculture 11 00186 g003

Orally Fed Recombinant Lactococcus lactis Displaying Surface Anti-Fimbrial Nanobodies Protects Piglets against Escherichia coli Causing Post-Weaning Diarrhea
Abstract
1. Introduction
2. Materials and Methods
2.1. Construction of Nb-ProtA Recombinant Fusion Genes
2.2. LR Reaction between pDONR221 Containing Nb-ProtA Insert and Gateway Adapted pTRKH3 Vector
2.3. Validation of Nb Surface Display on L. lactis
2.3.1. Slide Agglutination Assay
2.3.2. In vitro Villous Adhesion Assay
2.3.3. Fluorescence Microscopy of Recombinant L. lactis
2.4. In vivo Piglet Challenge Experiments
2.4.1. Animal Preparation
2.4.2. Feeding and Challenge
2.4.3. Monitoring Response
2.4.4. Statistical Analysis
3. Results
3.1. Cloning Nb for Surface-Display on L. lactis
3.2. In vitro Assay to Validate Nanobodies Surface Display on L. lactis
3.2.1. Agglutination Assay
3.2.2. Effect of Heat Treatment on Viability and Agglutination Capacity
3.2.3. Immunofluorescence Microscopy
3.2.4. In vitro Adhesion Assay
Lactococcus lactis Expressing anti-FedF Nanobodies
Lactococcus lactis Expressing anti-FaeG Nanobodies
3.3. In vivo Piglet Challenge Assay
3.3.1. Weight Gain
3.3.2. Fecal Bacterial Shedding and Diarrhea
3.3.3. Immune Response
4. Discussion
5. Conclusions
Supplementary Materials
Author Contributions
Funding
Institutional Review Board Statement
Informed Consent Statement
Data Availability Statement
Acknowledgments
Conflicts of Interest
Appendix A. Detailed Experiment Procedures
Appendix A.1. Primers Sequences
| Primer name | Nucleotide Sequence (5′-3′) |
| coc1 | GGGGACAAGTTTGTACAAAAAAGCAGGCTGAATTCAGAAAGGAGATATACGCATGAAAAAAAAGATTATCTCAGCTATTTTAATG |
| coc2 | AGATTATCTCAGCTATTTTAATGTCTACAGTGATACTTTCTGCTGCAGCCCCGTTGTCAGGTGTTTACGCTCAGGTGCAGCTGCAGGAGTCTG |
| coc3 | CTATTGGGGCCAGGGGACCCAGGTCACCGTCTCCTCAGGACCAAAAGAGGAAGACAATAACAAGCCT |
| coc4 | AGGCTTGTTATTGTCTTCCTCTTTTGGTCCTGAGGAGACGGTGACCTGGGTCCCCTGGCCCCAATAG |
| coc5 | GGGGACCACTTTGTACAAGAAAGCTGGGTAAAGCTTTTTATAGTTCGCGACGACGTCCAGCTAATA |
| coc19 | CTTTGTACAAAAAAGCAGGCTGAATTCAGAAAGGAGATATACGCATGAAAAAAAAGATTATCTCAGCTATTTTAATG |
| coc20 | GACCCAGGTCACCGTCTCCTCAGGACCAAAAGAG |
| Aida9 | GCGAAATTAATACGACTCACTATA |
| pETrev | GGTTATGCTAGTTATTGCTCAGCG |
| pTRKH8 | CTAATAAAGCCGTAAGGAGACGGGTTCA |
| pTRKH9 | CCCATCCTAACGGCCACG CATATG |
Appendix A.2. Construction of Nb-ProtA Recombinant Fusion Genes
Appendix A.3. Adapting pTRKH3 Vector to the Gateway System
Appendix A.4. Gibson Assembly Exchange Reaction
References
- Gyles, C.L. Escherichia coli in Domestic Animals and Humans; CAB International: Wallingford, Oxon, UK, 1994. [Google Scholar]
- Luppi, A.; Gibellini, M.; Gin, T.; Vangroenweghe, F.; Vandenbroucke, V.; Bauerfeind, R.; Bonilauri, P.; Labarque, G.; Hidalgo, Á. Prevalence of virulence factors in enterotoxigenic Escherichia coli isolated from pigs with post-weaning diarrhoea in Europe. Porc. Health Manag. 2016, 2, 20. [Google Scholar] [CrossRef] [PubMed]
- Duan, Q.; Yao, F.; Zhu, G. Major virulence factors of enterotoxigenic Escherichia coli in pigs. Ann. Microbiol. 2012, 62, 7–14. [Google Scholar] [CrossRef]
- Ho, W.S.; Tan, L.K.; Ooi, P.T.; Yeo, C.C.; Thong, K.L. Prevalence and characterization of verotoxigenic-Escherichia coli isolates from pigs in Malaysia. BMC Vet. Res. 2013, 9, 1–7. [Google Scholar] [CrossRef]
- Mainil, J. Escherichia coli virulence factors. Vet. Immunol. Immunopathol. 2013, 152, 2–12. [Google Scholar] [CrossRef]
- Toledo, A.; Gómez, D.; Cruz, C.; Carreón, R.; López, J.; Giono, S.; Castro, A.M. Prevalence of virulence genes in Escherichia coli strains isolated from piglets in the suckling and weaning period in Mexico. J. Med. Microbiol. 2012, 61, 148–156. [Google Scholar] [CrossRef]
- Zhang, W.; Zhao, M.; Ruesch, L.; Omot, A.; Francis, D. Prevalence of virulence genes in Escherichia coli strains recently isolated from young pigs with diarrhea in the US. Vet. Microbiol. 2007, 123, 145–152. [Google Scholar] [CrossRef] [PubMed]
- Imberechts, H.; De Greve, H.; Schlicker, C.; Bouchet, H.; Pohl, P.; Charlier, G.; Bertschinger, H.; Wild, P.; Vandekerckhove, J.; Van Damme, J.; et al. Characterization of F107 fimbriae of Escherichia coli 107/86, which causes edema disease in pigs, and nucleotide sequence of the F107 major fimbrial subunit gene, fedA. Infect. Immun. 1992, 60, 1963–1971. [Google Scholar] [CrossRef] [PubMed]
- Bergan, J.; Dyve Lingelem, A.B.; Simm, R.; Skotland, T.; Sandvig, K. Shiga toxins. Toxicon 2012, 60, 1085–1107. [Google Scholar] [CrossRef] [PubMed]
- Fleckenstein, J.M.; Hardwidge, P.R.; Munson, G.P.; Rasko, D.A.; Sommerfelt, H.; Steinsland, H. Molecular mechanisms of enterotoxigenic Escherichia coli infection. Microbes Infect. 2010, 12, 89–98. [Google Scholar] [CrossRef]
- Ou, B.; Jiang, B.; Jin, D.; Yang, Y.; Zhang, M.; Zhang, D.; Zhao, H.; Xu, M.; Song, H.; Wu, W.; et al. Engineered recombinant Escherichia coli probiotic strains integrated with f4 and f18 fimbriae cluster genes in the chromosome and their assessment of immunogenic efficacy in vivo. ACS Synth. Biol. 2020, 9, 412–426. [Google Scholar] [CrossRef]
- Verdonck, F.; Cox, E.; Van Gog, K.; Van der Stede, Y.; Duchateau, L.; Deprez, P.; Goddeeris, B.M. Different kinetic of antibody responses following infection of newly weaned pigs with an F4 enterotoxigenic Escherichia coli strain or an F18 verotoxigenic Escherichia coli strain. Vaccine 2002, 20, 2995–3004. [Google Scholar] [CrossRef]
- Cox, E.; Van Der Stede, Y.; Verdonck, F.; Snoeck, V.; Van Den Broeck, W.; Goddeeris, B. Oral immunisation of pigs with fimbrial antigens of enterotoxigenic E. coli: An interesting model to study mucosal immune mechanisms. Vet. Immuno. Immunopathol. 2002, 87, 287–290. [Google Scholar] [CrossRef]
- Moon, H.W.; Bunn, T.O. Vaccines for preventing enterotoxigenic Escherichia coli infections in farm animals. Vaccine 1993, 11, 213–220. [Google Scholar] [CrossRef]
- Melkebeek, V.; Goddeeris, B.M.; Cox, E. ETEC vaccination in pigs. Vet. Immunol. Immunopathol. 2013, 152, 37–42. [Google Scholar] [CrossRef]
- Verdonck, F.; Cox, E.; Van Der Stede, Y.; Goddeeris, B.M. Oral immunization of piglets with recombinant F4 fimbrial adhesin FaeG monomers induces a mucosal and systemic F4-specific immune response. Vaccine 2004, 22, 4291–4299. [Google Scholar] [CrossRef]
- Van Den Broeck, W.; Cox, E.; Goddeeris, B.M. Induction of immune responses in pigs following oral administration of purified F4 fimbriae. Vaccine 1999, 17, 2020–2029. [Google Scholar] [CrossRef]
- Verdonck, F.; Tiels, P.; van Gog, K.; Goddeeris, B.M.; Lycke, N.; Clements, J.; Cox, E. Mucosal immunization of piglets with purified F18 fimbriae does not protect against F18+ Escherichia coli infection. Vet. Immunol. Immunopathol. 2007, 120, 69–79. [Google Scholar] [CrossRef]
- Lee, W.J.; Cha, S.; Shin, M.; Jung, M.; Islam, M.A.; Cho, C.S.; Yoo, H.S. Efficacy of thiolated eudragit microspheres as an oral vaccine delivery system to induce mucosal immunity against enterotoxigenic Escherichia coli in mice. Eur. J. Pharm. Biopharm. 2012, 81, 43–48. [Google Scholar] [CrossRef]
- Snoeck, V.; Huyghebaert, N.; Cox, E.; Vermeire, A.; Vancaeneghem, S.; Remon, J.P.; Goddeeris, B.M. Enteric-coated pellets of F4 fimbriae for oral vaccination of suckling piglets against enterotoxigenic Escherichia coli infections. Vet. Immunol. Immunopathol. 2003, 96, 219–227. [Google Scholar] [CrossRef]
- Felder, C.B.; Vorlaender, N.; Gander, B.; Merkle, H.P.; Bertschinger, H.U. Microencapsulated enterotoxigenic Escherichia coli and detached fimbriae for peroral vaccination of pigs. Vaccine 2000, 19, 706–715. [Google Scholar] [CrossRef]
- Coddens, A.; Verdonck, F.; Tiels, P.; Rasschaert, K.; Goddeeris, B.M.; Cox, E. The age-dependent expression of the F18+ E. coli receptor on porcine gut epithelial cells is positively correlated with the presence of histo-blood group antigens. Vet. Microbiol. 2007, 122, 332–341. [Google Scholar] [CrossRef]
- Owusu-Asiedu, A.; Nyachoti, C.M.; Marquardt, R.R. Response of early-weaned pigs to an enterotoxigenic Escherichia coli (K88) challenge when fed diets containing spray-dried porcine plasma or pea protein isolate plus egg yolk antibody, zinc oxide, fumaric acid, or antibiotic. J. Anim. Sci. 2003, 81, 1790–1798. [Google Scholar] [CrossRef]
- Niewold, T.A.; van Dijk, A.J.; Geenen, P.L.; Roodink, H.; Margry, R.; van der Meulen, J. Dietary specific antibodies in spray-dried immune plasma prevent enterotoxigenic Escherichia coli F4 (ETEC) post weaning diarrhoea in piglets. Vet. Microbiol. 2007, 124, 362–369. [Google Scholar] [CrossRef] [PubMed]
- Jȩdrejek, D.; Levic, J.; Wallace, J.; Oleszek, W. Animal by-products for feed: Characteristics, European regulatory framework, and potential impacts on human and animal health and the environment. J. Anim. Feed Sci. 2016, 25, 189–202. [Google Scholar] [CrossRef]
- Hu, C.X.; Xu, Z.R.; Li, W.F.; Dong, N.; Lu, P.; Fu, L.L. Secretory expression of K88 (F4) fimbrial adhesin FaeG by recombinant Lactococcus lactis for oral vaccination and its protective immune response in mice. Biotechnol. Lett. 2009, 31, 991–997. [Google Scholar] [CrossRef]
- Wei, C.H.; Liu, J.K.; Hou, X.L.; Yu, L.Y.; Lee, J.S.; Kim, C.J. Immunogenicity and protective efficacy of orally or intranasally administered recombinant Lactobacillus casei expressing ETEC K99. Vaccine 2010, 28, 4113–4118. [Google Scholar] [CrossRef]
- Andersen, K.K.; Marcotte, H.; Álvarez, B.; Boyaka, P.N.; Hammarström, L. In situ gastrointestinal protection against anthrax edema toxin by single-chain antibody fragment producing lactobacilli. BMC Biotechnol. 2011, 11, 1–11. [Google Scholar] [CrossRef] [PubMed]
- Günaydin, G.; Zhang, R.; Hammarström, L.; Marcotte, H. Engineered Lactobacillus rhamnosus GG expressing IgG-binding domains of protein G: Capture of hyperimmune bovine colostrum antibodies and protection against diarrhea in a mouse pup rotavirus infection model. Vaccine 2014, 32, 470–477. [Google Scholar] [CrossRef]
- De Greve, H.; Virdi, V.; Bakshi, S.; Depicker, A. Simplified monomeric VHH-Fc antibodies provide new opportunities for passive immunization. Curr. Opin. Biotechnol. 2020, 61, 96–101. [Google Scholar] [CrossRef]
- Hamers-Casterman, C.; Atarhouch, T.; Muyldermans, S.; Robinson, G.; Hammers, C.; Songa, E.B.; Bendahman, N.; Hammers, R. Naturally occurring antibodies devoid of light chains. Nature 1993, 363, 446–448. [Google Scholar] [CrossRef] [PubMed]
- De Genst, E.; Saerens, D.; Muyldermans, S.; Conrath, K. Antibody repertoire development in camelids. Dev. Comp. Immunol. 2006, 30, 187–198. [Google Scholar] [CrossRef] [PubMed]
- Pinto Torres, J.E.; Goossens, J.; Ding, J.; Li, Z.; Lu, S.; Vertommen, D.; Naniima, P.; Chen, R.; Muyldermans, S.; Sterckx, Y.G.J.; et al. Development of a Nanobody-based lateral flow assay to detect active Trypanosoma congolense infections. Sci. Rep. 2018, 8, 1–15. [Google Scholar] [CrossRef]
- He, Y.; Ren, Y.; Guo, B.; Yang, Y.; Ji, Y.; Zhang, D.; Wang, J.; Wang, Y.; Wang, H. Development of a specific nanobody and its application in rapid and selective determination of Salmonella enteritidis in milk. Food Chem. 2020, 310, 125942. [Google Scholar] [CrossRef] [PubMed]
- Virdi, V.; Palaci, J.; Laukens, B.; Ryckaert, S.; Cox, E.; Vanderbeke, E.; Depicker, A.; Callewaert, N. Yeast-secreted, dried and food-admixed monomeric IgA prevents gastrointestinal infection in a piglet model. Nat. Biotechnol. 2019, 37, 527–530. [Google Scholar] [CrossRef] [PubMed]
- Harmsen, M.M.; Fijten, H.P.D.; Engel, B.; Dekker, A.; Eblé, P.L. Passive immunization with llama single-domain antibody fragments reduces foot-and-mouth disease transmission between pigs. Vaccine 2009, 27, 1904–1911. [Google Scholar] [CrossRef] [PubMed]
- Virdi, V.; Coddens, A.; De Buck, S.; Millet, S.; Goddeeris, B.M.; Cox, E.; De Greve, H.; Depicker, A. Orally fed seeds producing designer igas protect weaned piglets against enterotoxigenic Escherichia coli infection. Proc. Natl. Acad. Sci. USA 2013, 110, 11809–11814. [Google Scholar] [CrossRef]
- Harmsen, M.M.; van Solt, C.B.; Fijten, H.P.D.; van Keulen, L.; Rosalia, R.A.; Weerdmeester, K.; Cornelissen, A.H.M.; De Bruin, M.G.M.; Eblé, P.L.; Dekker, A. Passive immunization of guinea pigs with llama single-domain antibody fragments against foot-and-mouth disease. Vet. Microbiol. 2007, 120, 193–206. [Google Scholar] [CrossRef]
- Schmidt, D.J.; Beamer, G.; Tremblay, J.M.; Steele, J.A.; Kim, H.B.; Wang, Y.; Debatis, M.; Sun, X.; Kashentseva, E.A.; Dmitriev, I.P.; et al. A tetraspecific VHH-based neutralizing antibody modifies disease outcome in three animal models of Clostridium difficile infection. Clin. Vaccine Immunol. 2016, 23, 774–784. [Google Scholar] [CrossRef]
- Moonens, K.; De Kerpel, M.; Coddens, A.; Cox, E.; Pardon, E.; Remaut, H.; De Greve, H. Nanobody mediated inhibition of attachment of F18 fimbriae expressing Escherichia coli. PLoS ONE 2014, 9, e114691. [Google Scholar] [CrossRef]
- Moonens, K.; Van Den Broeck, I.; Okello, E.; Pardon, E.; De Kerpel, M.; Remaut, H.; De Greve, H. Structural insight in the inhibition of adherence of F4 fimbriae producing Enterotoxigenic Escherichia coli by llama single domain antibodies. Vet. Res. 2015, 46, 1–7. [Google Scholar] [CrossRef][Green Version]
- Leenhouts, K.; Buist, G.; Kok, J. Anchoring of proteins to Lactic acid bacteria. Antonie van Leeuwenhoek 1999, 76, 367. [Google Scholar] [CrossRef] [PubMed]
- O’Sullivan, D.J.; Klaenhammer, T.R. High- and low-copy-number Lactococcus shuttle cloning vectors with features for clone screening. Gene 1993, 137, 227–231. [Google Scholar] [CrossRef]
- Gasson, M.J. Plasmid complements of Streptococcus lactis NCDO 712 and other lactic streptococci after protoplast-induced curing. J. Bacteriol. 1983, 154, 1–9. [Google Scholar] [CrossRef]
- Cohen, S.; Sweeney, H.M. Modulation of protein A formation in Staphylococcus aureus by genetic determinants for methicillin resistance. J. Bacteriol. 1979, 140, 1028–1035. [Google Scholar] [CrossRef] [PubMed]
- Raleigh, E.A.; Trimarchi, R.; Revel, H. Genetic and physical mapping of the mcrA (rglA) and mcrB (rglB) loci of Escherichia coli K-12. Genetics 1989, 122, 279–296. [Google Scholar] [CrossRef]
- Cox, E.; Houvenaghel, A. Comparison of the in vitro adhesion of K88, K99, F41 and P987 positive Escherichia coli to intestinal villi of 4- to 5-week-old pigs. Vet. Microbiol. 1993, 34, 7–18. [Google Scholar] [CrossRef]
- Van Den Broeck, W.; Cox, E.; Goddeeris, B.M. Receptor-specific binding of purified F4 to isolated villi. Vet. Microbiol. 1999, 68, 255–263. [Google Scholar] [CrossRef]
- Okello, E.; Moonens, K.; Erume, J.; De Greve, H. Enterotoxigenic Escherichia coli strains are highly prevalent in Ugandan piggeries but disease outbreaks are masked by antibiotic prophylaxis. Trop. Anim. Health Prod. 2014, 47, 117–122. [Google Scholar] [CrossRef]
- McCracken, A.; Turner, M.S.; Giffard, P.; Hafner, L.M.; Timms, P. Analysis of promoter sequences from Lactobacillus and Lactococcus and their activity in several Lactobacillus species. Arch. Microbiol. 2000, 173, 383–389. [Google Scholar] [CrossRef]
- Esko, J.D.; Doering, T.L.; Raetz, C.R. Eubacteria and Archaea. In Essentials of Glycobiology, 2nd ed.; Varki, A., Cummings, R.D., Esko, J.D., Freeze, H.H., Stanley, P., Bertozzi, C.R., Hart, G.W., Etzler, M.E., Eds.; Cold Spring Harbor Laboratory Press: New York, NY, USA, 2009; Chapter 20; ISBN 9780879697709. [Google Scholar]
- Schneewind, O.; Fowler, A.; Faull, K.F. Structure of the cell wall anchor of surface proteins in Staphylococcus aureus. Science 1995, 268, 103–106. [Google Scholar] [CrossRef]
- Pant, N.; Hultberg, A.; Zhao, Y.; Svensson, L.; Pan-Hammarström, Q.; Johansen, K.; Pouwels, P.H.; Ruggeri, F.M.; Hermans, P.; Frenken, L.; et al. Lactobacilli expressing variable domain of Llama Heavy-chain antibody fragments (Lactobodies) confer protection against Rotavirus-induced diarrhea. J. Infect. Dis. 2006, 194, 1580–1588. [Google Scholar] [CrossRef]
- De Greve, H.; Wyns, L.; Bouckaert, J. Combining sites of bacterial fimbriae. Curr. Opin. Struct. Biol. 2007, 17, 506–512. [Google Scholar] [CrossRef]
- Van Den Broeck, W.; Cox, E.; Goddeeris, B.M. Receptor-dependent immune responses in pigs after oral immunization with F4 fimbriae. Infect. Immun. 1999, 67, 520–526. [Google Scholar] [CrossRef] [PubMed]
- Klein, A.; Friedrich, U.; Vogelsang, H.; Jahreis, G. Lactobacillus acidophilus 74-2 and Bifidobacterium animalis subsp lactis DGCC 420 modulate unspecific cellular immune response in healthy adults. Eur. J. Clin. Nutr. 2008, 62, 584–593. [Google Scholar] [CrossRef]
- Konstantinov, S.R.; Awati, A.A.; Williams, B.A.; Miller, B.G.; Jones, P.; Stokes, C.R.; Akkermans, A.D.L.; Smidt, H.; de Vos, W.M. Post-natal development of the porcine microbiota composition and activities. Environ. Microbiol. 2006, 8, 1191–1199. [Google Scholar] [CrossRef]
- Lallès, J.P.; Bosi, P.; Smidt, H.; Stokes, C.R. Weaning—A challenge to gut physiologists. Livest. Sci. 2007, 108, 82–93. [Google Scholar] [CrossRef]
- Rasschaert, K.; Verdonck, F.; Goddeeris, B.M.; Duchateau, L.; Cox, E. Screening of pigs resistant to F4 enterotoxigenic Escherichia coli (ETEC) infection. Vet. Microbiol. 2007, 123, 249–253. [Google Scholar] [CrossRef] [PubMed]
- Miller, J. Experiments in Molecular Genetics; Cold Spring Harbor Laboratory: New York, NY, USA, 1972; ISBN 9780879691066. [Google Scholar]
- Salmon, M.A.; Van Melderen, L.; Bernard, P.; Couturier, M. The antidote and autoregulatory functions of the F plasmid CcdA protein: A genetic and biochemical survey. MGG Mol. Gen. Genet. 1994, 244, 530–538. [Google Scholar] [CrossRef] [PubMed]
- Gibson, D.G.; Young, L.; Chuang, R.Y.; Venter, J.C.; Hutchison, C.A.; Smith, H.O. Enzymatic assembly of DNA molecules up to several hundred kilobases. Nat. Methods 2009, 6, 343–345. [Google Scholar] [CrossRef]

| Group | Number | Treatment | L. lactis Dose |
|---|---|---|---|
| 1 (Negative control) | 5 | No F4 ETEC given | No L. lactis added |
| 2 (Positive control) | 5 | F4 ETEC + MG1363 L. lactis | 1010 cells/100g of feed |
| 3 (Test) | 10 | F4 ETEC + Anti-F4 L. lactis | 1010 cells/100g of feed |
| Anti-FaeG L. lactis Strains | Anti-FedF L. lactis Strains | ||
|---|---|---|---|
| Long Anchor ProtA | Short Anchor ProtA | Long Anchor ProtA | Short Anchor ProtA |
| pEXP366 (V2) | pEXP444 (V2) | pEXP362-1 (NbFedF6) | pEXP447 (NbFedF9) |
| pEXP368 (V4) | pEXP445 (V3) | pEXP364-3 (NbFedF7) | pEXP451 (NbFedF12) |
| pEXP441 (V1) | pEXP455 (V1) | pEXP459 (NbFedF9) | pEXP449 (NbFedF11) |
| pEXP457 (V4) | pEXP463 (NbFedF12) | pEXP365 (NbFedF7) | |
| pEXP461 (NbFedF11) | pEXP363 (NbFedF6) | ||
Publisher’s Note: MDPI stays neutral with regard to jurisdictional claims in published maps and institutional affiliations. |
© 2021 by the authors. Licensee MDPI, Basel, Switzerland. This article is an open access article distributed under the terms and conditions of the Creative Commons Attribution (CC BY) license (http://creativecommons.org/licenses/by/4.0/).
Share and Cite
Okello, E.; Moonens, K.; Erume, J.; De Greve, H. Orally Fed Recombinant Lactococcus lactis Displaying Surface Anti-Fimbrial Nanobodies Protects Piglets against Escherichia coli Causing Post-Weaning Diarrhea. Agriculture 2021, 11, 186. https://doi.org/10.3390/agriculture11030186
Okello E, Moonens K, Erume J, De Greve H. Orally Fed Recombinant Lactococcus lactis Displaying Surface Anti-Fimbrial Nanobodies Protects Piglets against Escherichia coli Causing Post-Weaning Diarrhea. Agriculture. 2021; 11(3):186. https://doi.org/10.3390/agriculture11030186
Chicago/Turabian StyleOkello, Emmanuel, Kristof Moonens, Joseph Erume, and Henri De Greve. 2021. "Orally Fed Recombinant Lactococcus lactis Displaying Surface Anti-Fimbrial Nanobodies Protects Piglets against Escherichia coli Causing Post-Weaning Diarrhea" Agriculture 11, no. 3: 186. https://doi.org/10.3390/agriculture11030186
APA StyleOkello, E., Moonens, K., Erume, J., & De Greve, H. (2021). Orally Fed Recombinant Lactococcus lactis Displaying Surface Anti-Fimbrial Nanobodies Protects Piglets against Escherichia coli Causing Post-Weaning Diarrhea. Agriculture, 11(3), 186. https://doi.org/10.3390/agriculture11030186

